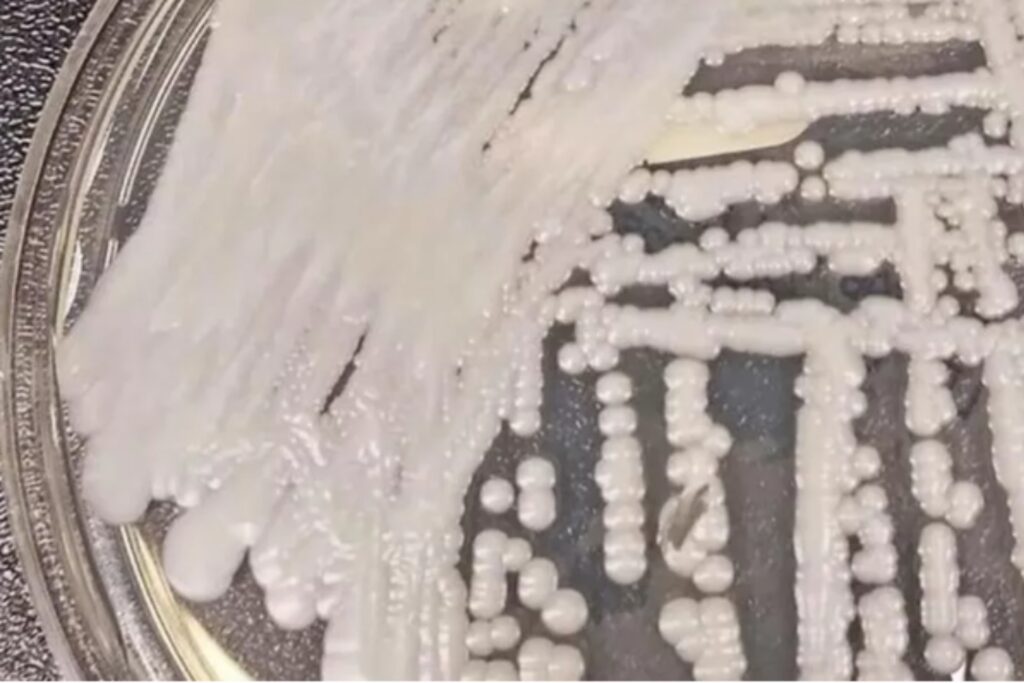

MPF encontra documentos da ditadura no antigo IML do Rio

O MPF encontrou documentos históricos da ditadura militar no antigo IML do Rio. O material pode esclarecer o paradeiro de desaparecidos políticos e revelar novas informações sobre violações de direitos humanos. Após a inspeção, especialistas destacaram a importância de preservar o acervo e propuseram medidas para garantir sua conservação.
Elon Musk conclui fusão entre xAI e X em um negócio de US$ 45 bilhões

Elon Musk finalizou a fusão entre xAI e X em um negócio de US$ 45 bilhões. A transação fortalece a sinergia entre inteligência artificial e redes sociais, elevando a avaliação conjunta das empresas para US$ 80 bilhões.
Brasil enfrenta avanço de superfungos resistentes em hospitais e na comunidade
O Brasil enfrenta o avanço dos superfungos Candida auris e Trichophyton indotineae, que apresentam alta resistência aos tratamentos convencionais. O primeiro tem causado surtos hospitalares em São Paulo e pode ser fatal para pacientes imunossuprimidos. O segundo provoca micoses persistentes e de difícil tratamento, com casos já identificados no país. Especialistas alertam para a necessidade de controle rigoroso, diagnóstico precoce e uso adequado de antifúngicos para conter a disseminação.
Trump ameaça bombardear Irã se acordo nuclear fracassar

Donald Trump ameaçou bombardear o Irã se o país não aceitar um novo acordo nuclear. O presidente americano também mencionou tarifas secundárias como forma de pressão econômica. O Irã rejeitou a imposição e respondeu diplomaticamente por meio de Omã. A crise se intensificou após a saída dos EUA do acordo nuclear de 2015, levando Teerã a expandir seu programa de enriquecimento de urânio.
Homem é preso após agredir companheira em Paraíba do Sul

Em Paraíba do Sul, homem foi preso após agredir sua companheira. Ele foi autuado com base na Lei Maria da Penha e permanece à disposição da Justiça.
Polícia Federal prende homem condenado por posse de moeda falsa e corrupção de menores em Macaé

A Polícia Federal prendeu, em Macaé, um homem condenado por posse de moeda falsa e corrupção de menores. Ele cumprirá pena de cinco anos e sete meses no regime fechado.
Empório 1839 chega ao Jardim Botânico com opções de café da manhã e cardápio variado

O Empório 1839, novo restaurante e padaria no Jardim Botânico, oferece uma excelente variedade de pães, crepiocas, bowls de açaí e bebidas para todos os gostos. A casa funciona todos os dias, das 6h às 20h.
Ibama combate tráfico de animais silvestres em Duque de Caxias e apreende 194 espécies

A Operação Mercatio apreendeu 194 animais silvestres na Feira de Duque de Caxias, incluindo espécies ameaçadas de extinção. O Ibama aplicou R$ 270,5 mil em multas e prendeu três pessoas por crimes ambientais. Os animais foram levados para centros de reabilitação, enquanto os caranguejos foram soltos em áreas de preservação. A fiscalização contra o tráfico de animais continuará sendo reforçada.
Feira O Fuxico agita Ipanema com música, gastronomia e moda nos dias 5 e 6 de abril

Feira O Fuxico, nos dias 5 e 6 de abril, oferece música, gastronomia, moda e atividades para crianças na Praça Nossa Senhora da Paz, em Ipanema. Entrada gratuita.
Pitbull abandonada ataca animais em Bangu e é resgatada pela Prefeitura

Uma pitbull foi resgatada em Bangu após atacar outros animais. Abandonada na comunidade do 77, ela foi amarrada por moradores até o resgate da Prefeitura. Encaminhada ao CCZ, receberá tratamento antes de ser disponibilizada para adoção. A Fazenda Modelo enfrenta superlotação e apela para a adoção responsável.